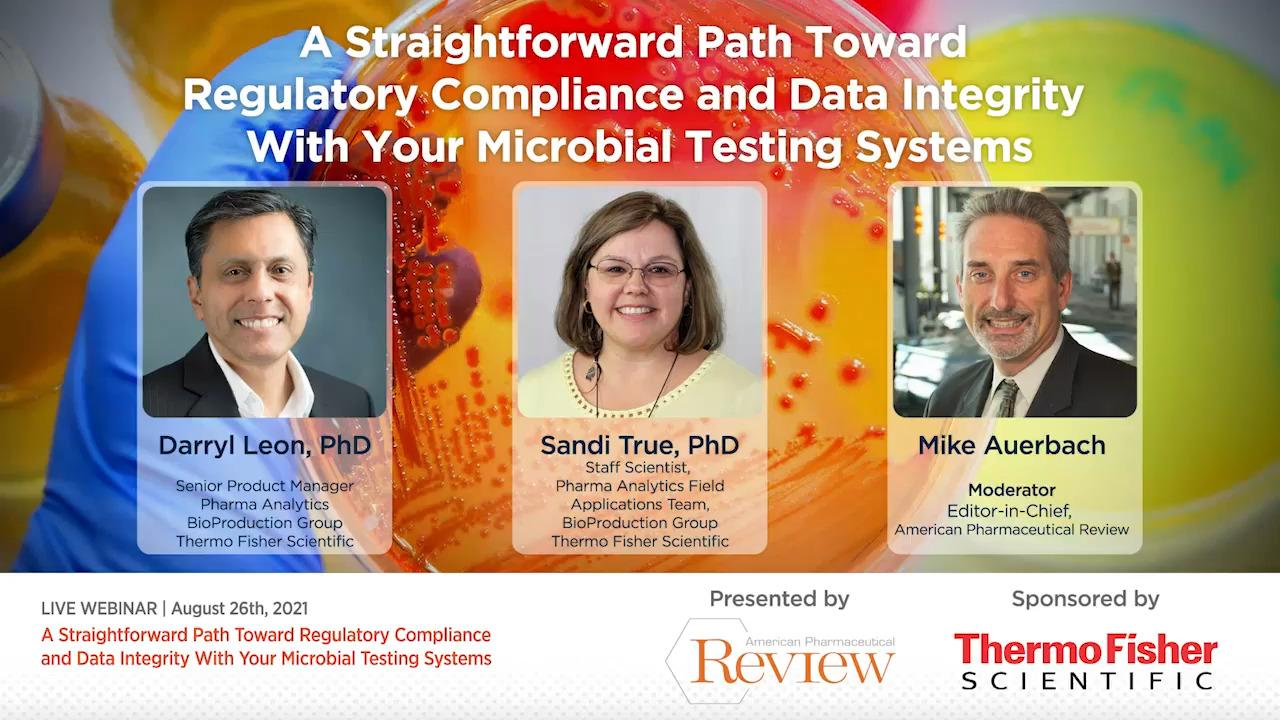

Search
Designed to support regulatory guidelines
FDA guidance is intended to help manufacturers meet the requirements in the Agency's current good manufacturing practice (CGMP) regulations (21 CFR parts 210 and 211) when manufacturing sterile drug and biological products using aseptic processing. In the guidance document, Sterile Drug Products Produced by Aseptic Processing—Current Good Manufacturing Practice, the FDA clearly identifies genotypic methods of microbial identification to be more accurate and precise than traditional biochemical and phenotypical techniques.
MicroSEQ ID is designed to support the recommended qualification guidelines from:
- International Conference on Harmonization (ICH)
- United States Pharmacopeia (USP)
- European Pharmacopoeia (EUP)
- Japanese Pharmacopoeia (JP)
Installation and Operation Qualification (IQ/OQ) Service
Helping you validate your system quickly and efficiently, the IQ/OQ Service provides qualification of the fully integrated MicroSEQ Rapid Microbial Identification System, including documentation.
This service offers:
- Client consultation to determine training needs, system installation, and validation timelines and plans
- System hardware and software installation and operation
- Software security and audit trail verification
- Installation Qualification (IQ) Protocol and Service: ~2 days
- Operational Qualification (OQ) Protocol and Service: ~3 days
- Performance qualification (PQ) recommended guidelines
Implementation Program
Need help with lab design, setup, and technician training? The MicroSEQ ID Implementation Program helps customize laboratory design and provides workflow training to meet the specific needs of your lab, including:
- Laboratory workflow consultation and setup assistance based on good molecular biology lab practices
- Introduction to the basics of DNA-based vs. traditional culture methods
- Multiple visits by a specialist over a 6-month period
- Hands-on sessions on the MicroSEQ ID system workflow
- Guidance in establishing data acceptance criteria and interpretation
- Detailed analysis of flow from data collection to identification
- Workflow design to maximize efficiency for variable sample throughput
- Software training and system routine maintenance
Request a technical consultation
No matter your questions, we are here to help. Our experienced team of scientists and technical specialists is ready to assist you in choosing the right solution and products. Complete this form to start the conversation.
Analytics Knowledge Hub
Explore the Analytics Knowledge Hub and discover a robust collection of webinars, articles, eBooks, infographics, and other digital resources to help you optimize analytical testing in your bioprocess workflow.
Additional bioprocessing resources
Bioprocessing resources
For Research Use Only. Not for use in diagnostic procedures.